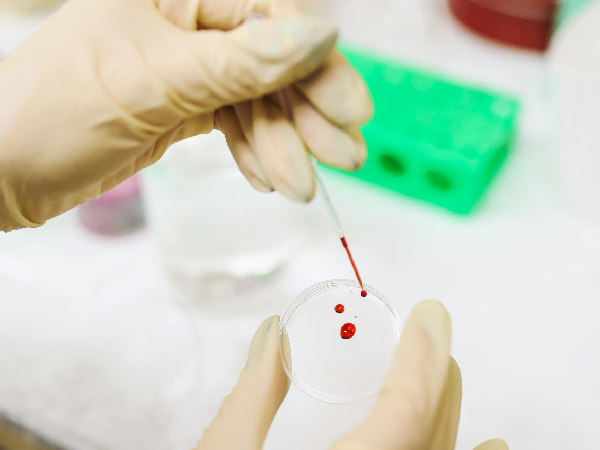
A Discovery Of A Rare Blood Type

Latest Updates
-
Purported Video of Muslim Mob Lynching & Hanging Hindu Youth In Bangladesh Shocks Internet -
A Hotel on Wheels: Bihar Rolls Out Its First Luxury Caravan Buses -
Bharti Singh-Haarsh Limbachiyaa Welcome Second Child, Gender: Couple Welcome Their Second Baby, Duo Overjoyed - Report | Bharti Singh Gives Birth To Second Baby Boy | Gender Of Bharti Singh Haarsh Limbachiyaa Second Baby -
Bharti Singh Welcomes Second Son: Joyous News for the Comedian and Her Family -
Gold & Silver Rates Today in India: 22K, 24K, 18K & MCX Prices Fall After Continuous Rally; Check Latest Gold Rates in Chennai, Mumbai, Bangalore, Hyderabad, Ahmedabad & Other Cities on 19 December -
Nick Jonas Dancing to Dhurandhar’s “Shararat” Song Goes Viral -
From Consciousness To Cosmos: Understanding Reality Through The Vedic Lens -
The Sunscreen Confusion: Expert Explains How to Choose What Actually Works in Indian Weather -
On Goa Liberation Day 2025, A Look At How Freedom Shaped Goa Into A Celebrity-Favourite Retreat -
Daily Horoscope, Dec 19, 2025: Libra to Pisces; Astrological Prediction for all Zodiac Signs
Could You Have This Rare Blood Group? The One You Didn’t Know Existed!
In an exciting development, scientists from the UK and Israel have discovered a new human blood group system, marking a significant milestone in medical science. This discovery, nearly five decades in the making, promises to improve care for people with rare blood types and adds a fascinating new layer to our understanding of the human body.
The Mystery That Sparked Decades Of Research
The journey began in 1972 with a pregnant woman whose blood was missing a molecule found in every known blood type. This unusual case puzzled doctors and set off decades of research, eventually leading to the discovery of the MAL blood group system. This rare anomaly prompted scientists to dig deeper into the complexities of blood.
Years Of Dedication Pay Off
Louise Tilley, a hematologist with the UK's National Health Service, called this discovery a major achievement. After nearly 20 years of dedicated research, scientists can now offer better care for people with rare blood types. This breakthrough demonstrates the power of persistence and teamwork in advancing medical knowledge.
Beyond The Basics : The Complexity Of Blood Types
While most people are familiar with the ABO and Rh blood groups, the truth is that blood types are far more complex. Blood contains various proteins and sugars that help the body recognize what belongs and what doesn't. Mismatches in these markers during a transfusion can lead to severe reactions, making the discovery of new blood groups like MAL crucial.
Tackling A Rare Genetic Challenge
Uncovering the MAL blood group wasn't easy. The AnWj antigen, which was missing in the 1972 case, is present in over 99.9% of people. Its absence is due to mutations in the MAL gene. Because of its rarity, scientists faced significant challenges in identifying and confirming this new blood group system.
The Pivotal Experiment
Tim Satchwell, a cell biologist, explained the critical experiment that validated their findings. By inserting the normal MAL gene into cells that lacked the AnWj antigen, researchers were able to reintroduce the missing molecule, proving the genetic basis of this blood group. This breakthrough was key to understanding the MAL blood group system.
Unique Features Of The MAL Blood Group
One intriguing aspect of the MAL blood group is that the AnWj antigen isn't present at birth but appears shortly after. Despite this rare mutation, individuals with AnWj-negative blood don't show any other health issues, indicating the mutation's isolated effect. This makes the discovery all the more fascinating and significant.
Implications For Patient Care
With this discovery, doctors can now test for this rare blood type, helping them better diagnose and manage patients. Knowing whether the absence of the AnWj antigen is inherited or due to another condition is crucial in preventing dangerous transfusion reactions and improving patient outcomes.
A Major Leap Forward
The discovery of the MAL blood group is a groundbreaking achievement in medical science. It not only deepens our understanding of human biology but also paves the way for better, safer care for individuals with rare blood types. Published in the journal Blood, this finding marks an important step forward in the quest to unravel the mysteries of human blood.
Disclaimer: The information provided in this article is for general informational and educational purposes only and is not intended as a substitute for professional medical advice, diagnosis, or treatment. Always seek the advice of your physician or a qualified healthcare provider with any questions you may have regarding a medical condition.



Click it and Unblock the Notifications